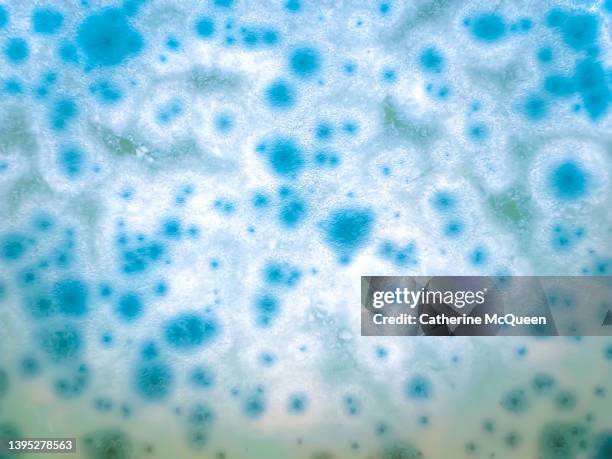
full frame of mold growth - mofo imagens e fotografias de stock

7870 fotografias de stock e imagens de alta resolução sobre Mofo
Pesquise 7.870 fotografias de stock autênticas, imagens de alta resolução e fotos sobre mofo, ou explore imagens adicionais sobre cogumelo ou alga verdestock para encontrar a fotografia certa com o tamanho e a resolução certos para o seu projeto.

Pesquisas relacionadas:
SEGUINTE